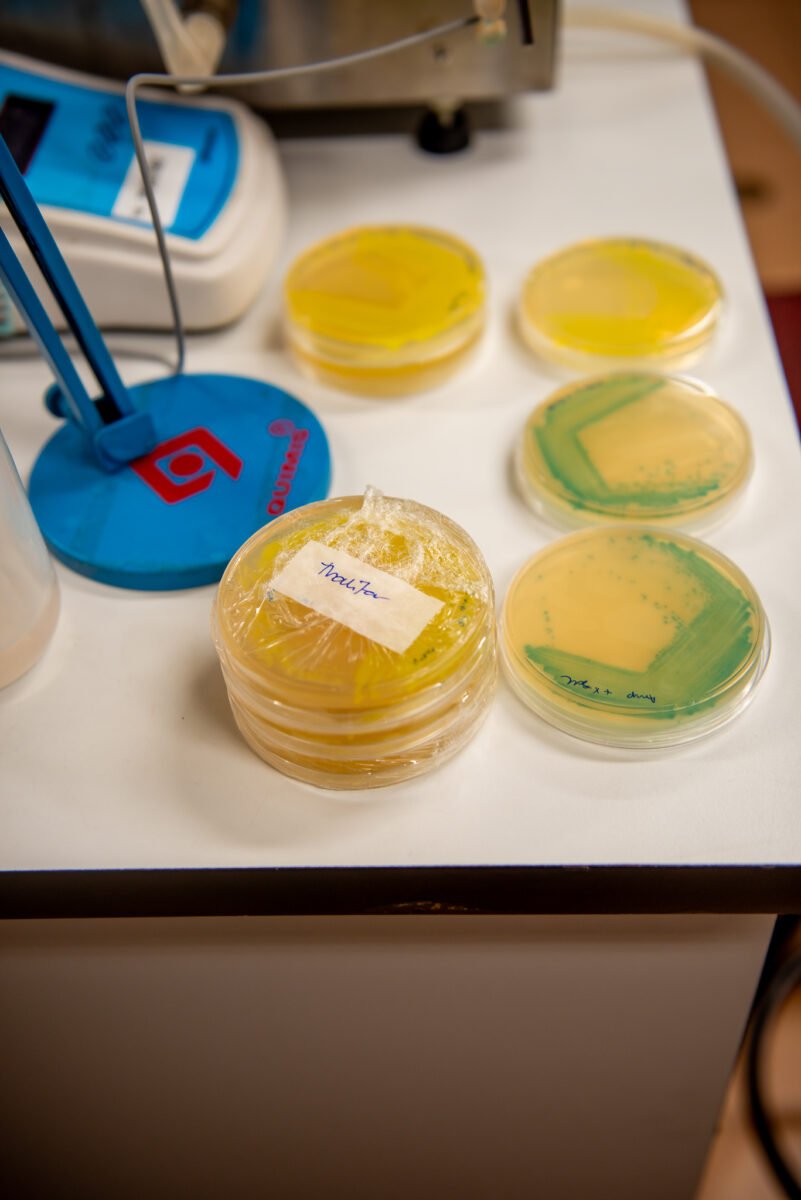
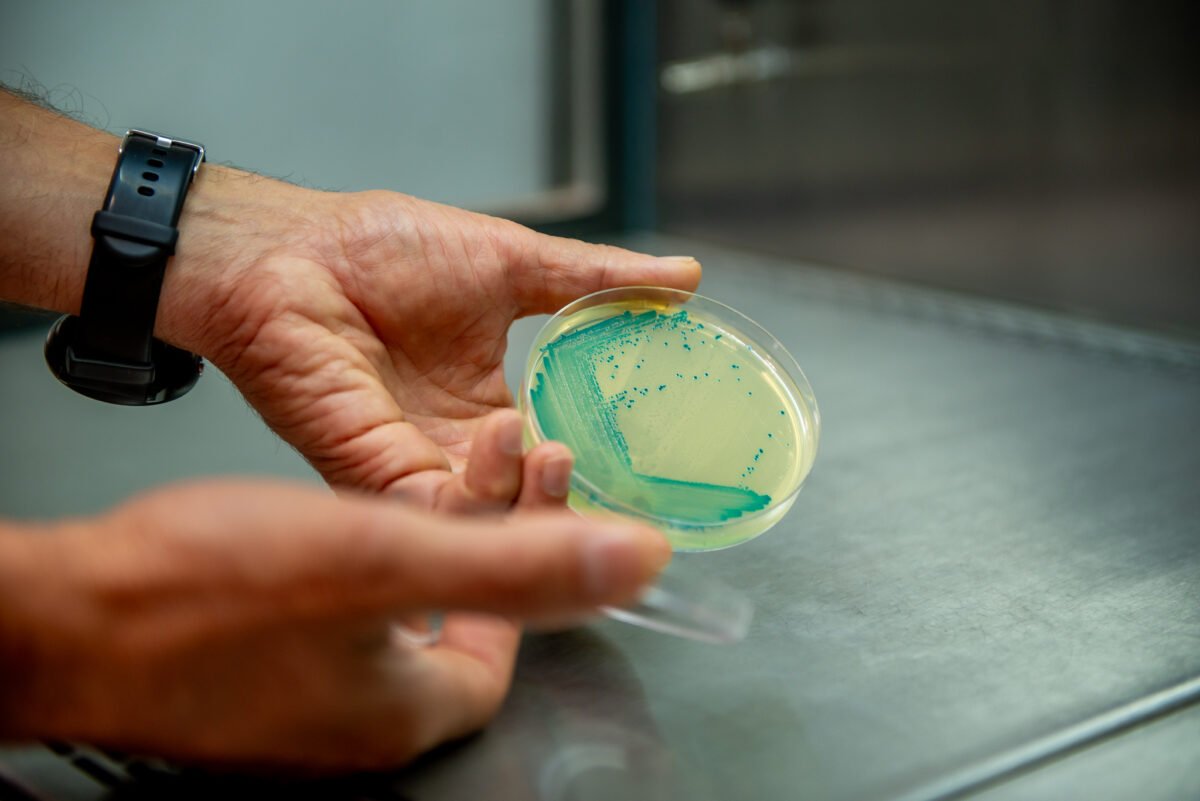
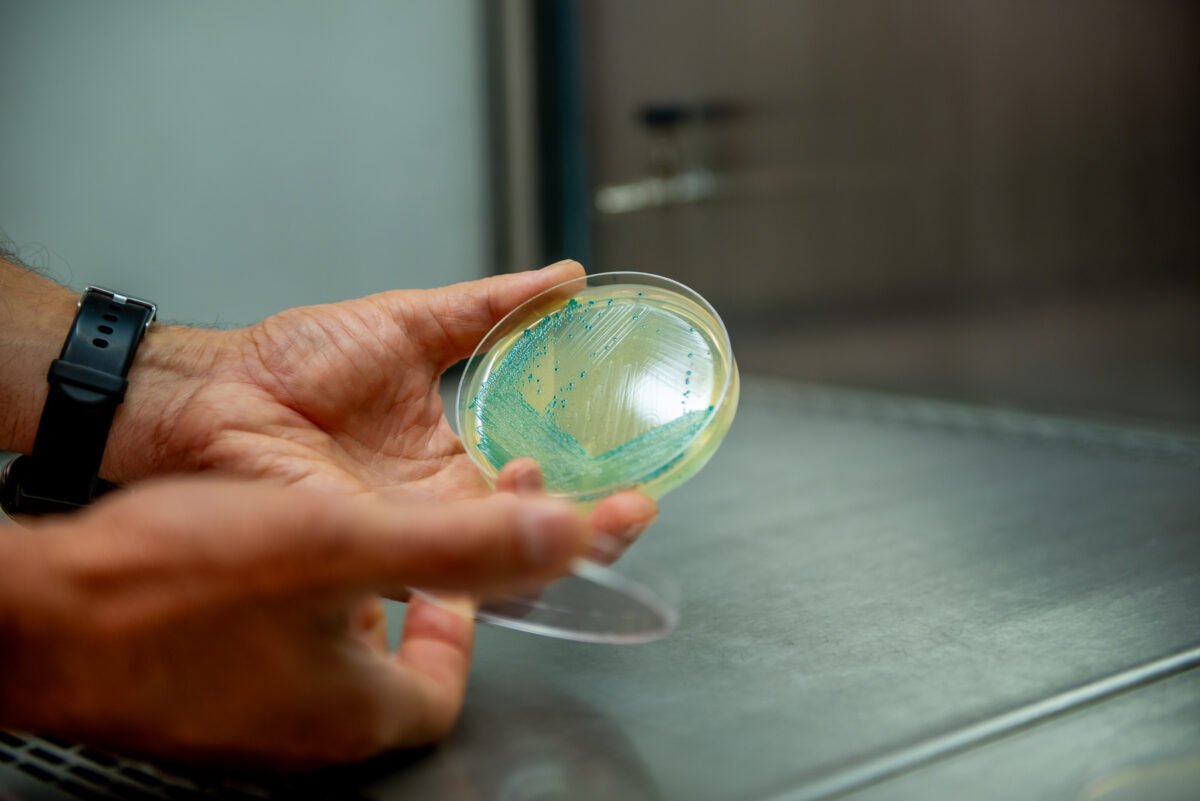

Bactérias fixadoras de nitrogênio são microrganismos encontrados naturalmente em raízes de plantas como milho, trigo, cana-de-açúcar e arroz. Seu papel de fixar nitrogênio e liberá-lo para a planta permite a redução do uso de fertilizantes, um dos insumos mais caros na agricultura. Ainda que descobertas há cerca de 130 anos, estudos recentes têm ampliado as possibilidades de sua utilização e aprimorado seu desempenho.
É o caso da bactéria HM053, uma cepa que pertence à espécie Azospirillum brasilense, que foi selecionada pelo professor do Programa de Pós-Graduação em Bioquímica da Universidade Federal do Paraná (UFPR), Fábio de Oliveira Pedrosa, e seu então aluno de mestrado, Hidevaldo Bueno Machado.
Isso ocorreu em 1987, no Núcleo de Fixação Biológica de Nitrogênio, por uma técnica chamada evolução adaptativa. Essa estirpe tem uma capacidade de fixar nitrogênio aumentada muitas vezes em decorrência do processo de seleção.
“A partir do isolamento e da caracterização de mutantes de Azospirillum brasilense resistentes a etilenodiamina, selecionamos quatro estirpes para caracterização bioquímica, fisiológica e genética. Todas foram capazes de fixar nitrogênio”, pontua Pedrosa.
Esse processo levou em torno de dois anos, considerando todas as etapas pelas quais o experimento passou. Para isso, a bactéria parental, chamada de “mãe”, foi colocada em condições nas quais precisou se ajustar para sobreviver. Tais condições permitiram a seleção de bactérias “filhas”, com características otimizadas.
“Foram usadas três condições distintas para identificar qual seria capaz de selecionar a melhor bactéria. A partir dessas três condições, foram isoladas cerca de 600 bactérias ‘filhas’ e cada um delas passou por uma bateria de vários testes para identificarmos as melhores. Dessas ‘filhas’, quatro foram selecionadas, e, das quatro, elegemos a HM053 por produzir grande quantidade de amônia”, explica Emanuel Maltempi de Souza, professor do Departamento de Bioquímica e Biologia Molecular da UFPR e cientista do Núcleo de Fixação Biológica de Nitrogênio da UFPR.
Depois do sequenciamento do genoma da HM053 e de várias análises, os cerca de 20 pesquisadores da UFPR que, de alguma forma, contribuíram com o estudo, identificaram a mudança genômica que levou ao fenótipo único dessa bactéria. Souza conta que apenas duas décadas depois é que foram compreender melhor as novas características da bactéria.
“Hoje entendemos bem o que está ocorrendo e temos condições inclusive de melhorar ainda mais suas características. Isso sem a produção de bactérias transgênicas, mas utilizando técnicas clássicas e edição gênica”.
Experimentos apontaram que além do alto potencial de fixação de nitrogênio, a HM053 tem capacidade aumentada de produzir compostos estimulantes do crescimento vegetal, ou seja, fitormônios.
“Deste modo, a bactéria estimula o crescimento e o desenvolvimento da planta, além de fornecer a ela um nutriente essencial. Como contrapartida, a planta libera exsudatos, uma mistura de compostos que incluem nutrientes e outras substâncias benéficas para a bactéria”, esclarece o estudioso.
Segundo o professor, testes em campo em associação com outros cientistas comprovaram que a HM053 aumentou a produtividade de milho em até 28%.
“Salientamos que as condições de campo são muito mais complexas e variáveis do que as do laboratório, portanto é possível que outros fatores que ainda não avaliamos sejam importantes para o efeito observado na produtividade”, revela.
(Continua)
Acesse na revista Ciência UFPR, com links: https://ciencia.ufpr.br/portal/ja-disponivel-no-mercado-bacteria-biotecnologica-aumenta-produtividade-do-milho/